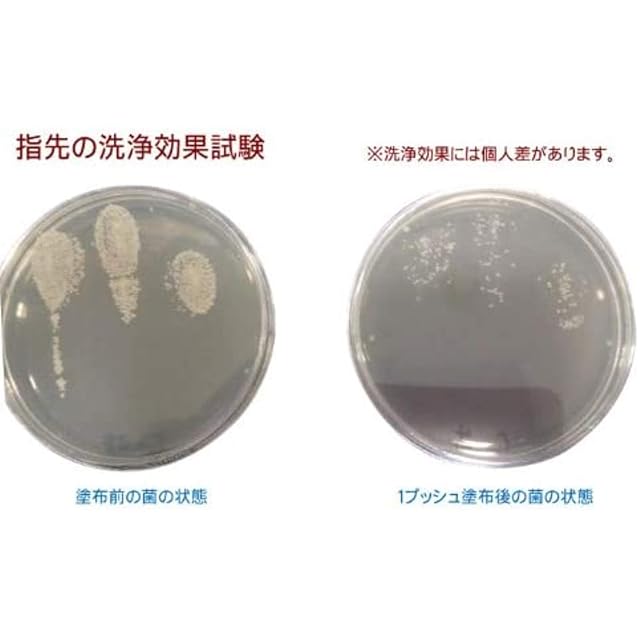

・翌月にまとめてお支払い可能
・手数料無料(口座振替の場合)
・アプリでご利用金額を確認できて安心

¥4,787 税込
なら 手数料無料の 翌月払いでOK
この商品は送料無料です。
【商品概要】
内容量 150ml(1本あたり) × 3本セット
【商品説明】
ルバンシュ「水のいらないボディ&ヘアウォッシュ」は、水のないところで使える、食用成分100%の全身用洗浄料(シャンプー&ボディソープ兼用)です。<br> <br> 水を必要としないので、忙しい朝や入浴ができない時に、洗い流し不要のシャンプーとして頭皮やからだ全体にお使いいただけます。さわやかな天然の香りと、べたつくことがない使用感が特徴です。<br> <br> ペット用のシャンプーにも使えます 水や石けんがなくても手をきれいに保つための洗浄剤としてや、ペット用のシャンプーとしてもつかえ、幅広い用途でご利用いただけます。<br> <br> 泡で出てくるので、液だれがありません。 もちろん、人間が長く入浴できないときなどに使うのにも適しています。また、出かけた際の手肌の洗浄などにも使えます。<br> <br>
【商品詳細】
ブランド:ルバンシュ
商品種別:ボディソープ
商品名:ルバンシュ 水のいらないボディ&ヘアウォッシュ × 3本セット
商品内容:150ミリリットル (x 3)
梱包サイズ:45.1cm
レビュー
(72)
送料・配送方法について
お支払い方法について